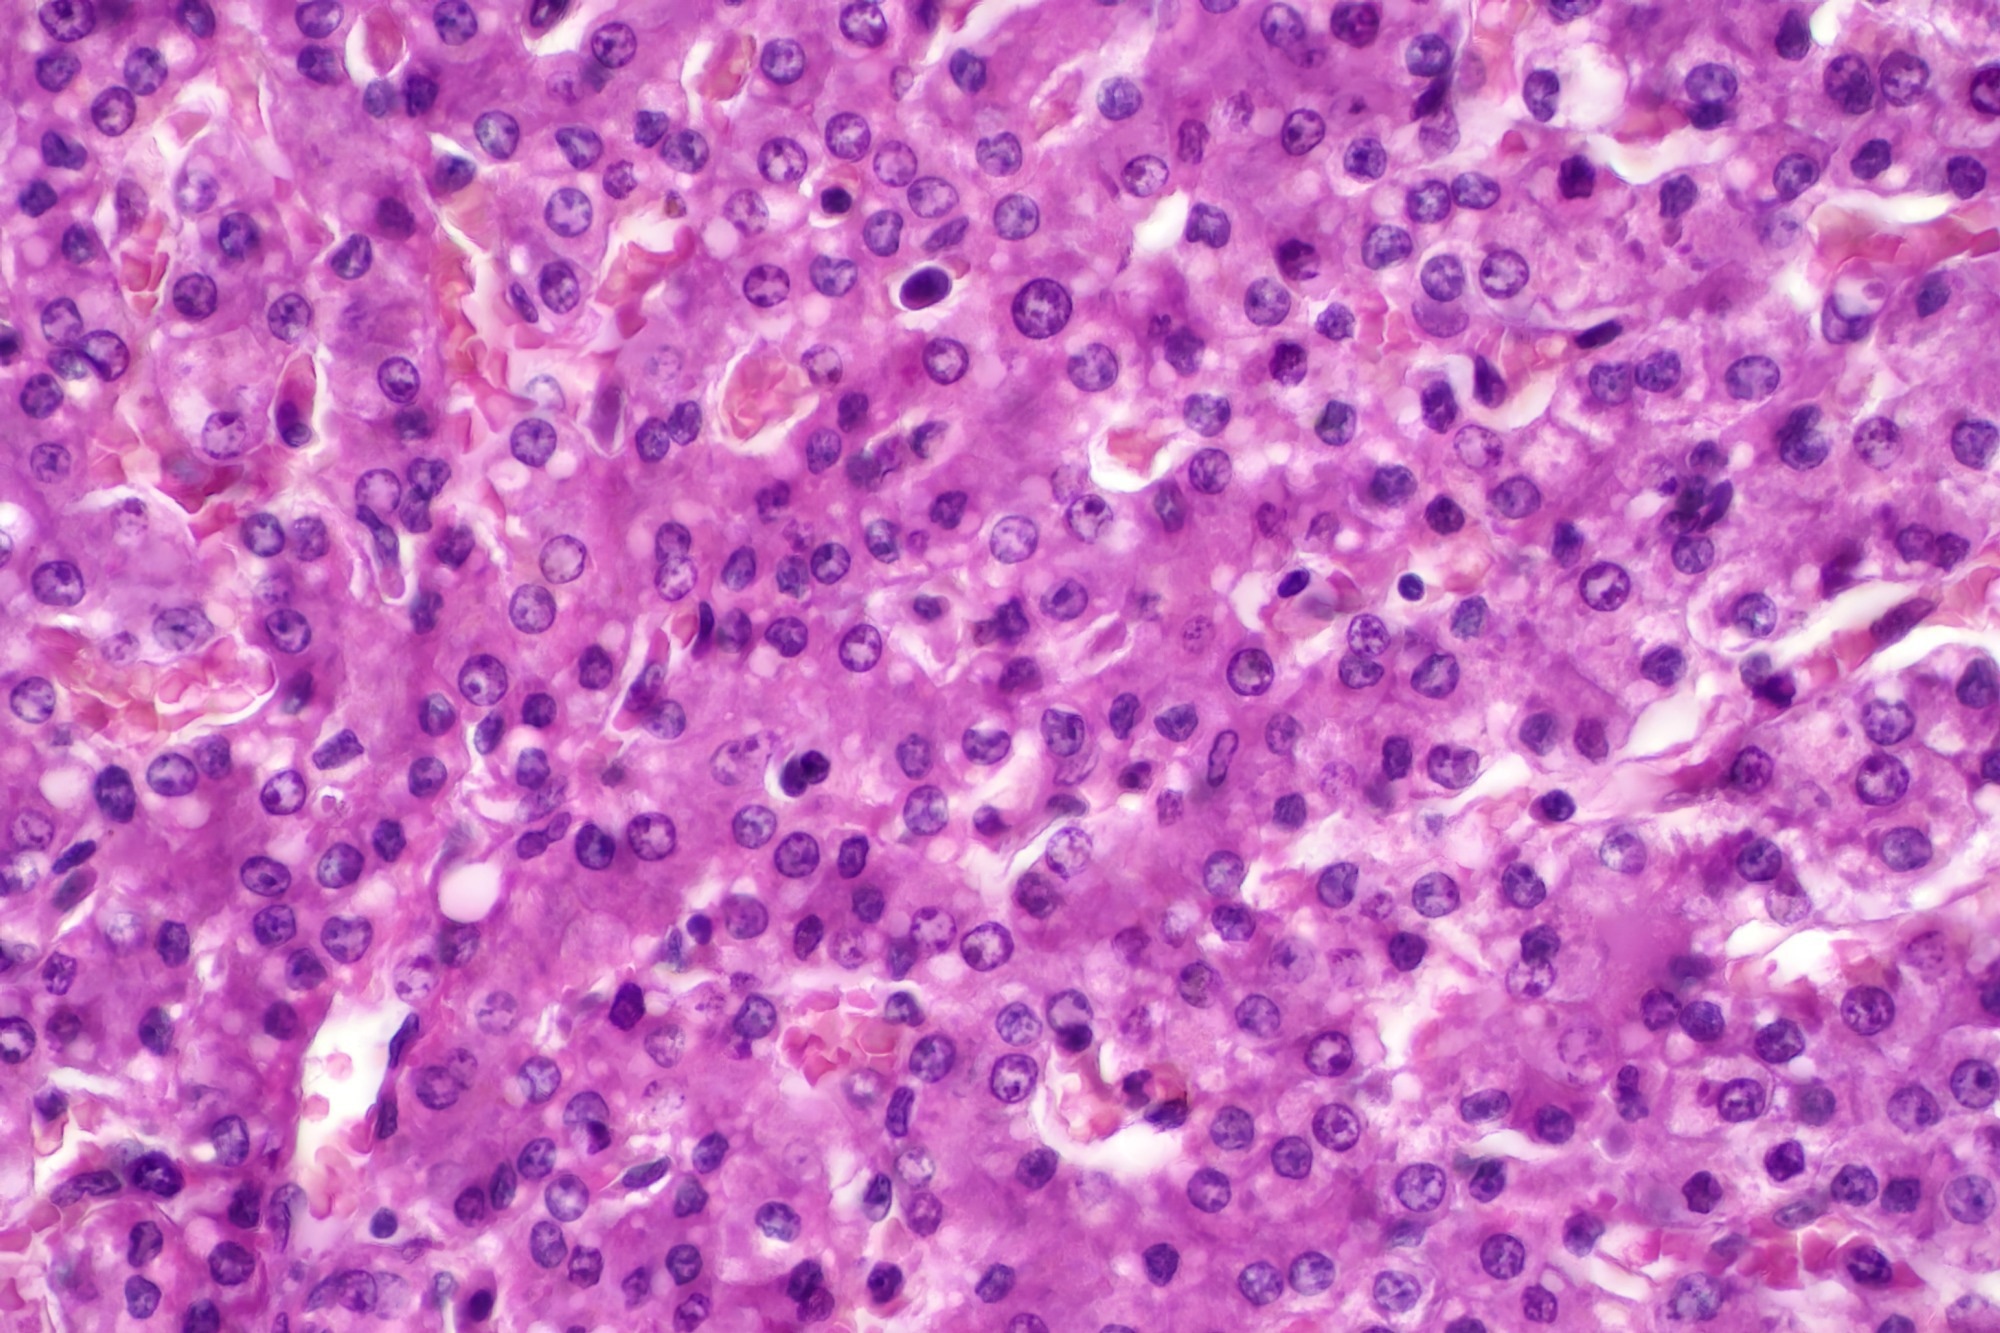
Image Credit: Choksawatdikorn/Shutterstock.com

In this interview, Dan Schieffer, Scientific Director at DeNovix, discusses how customer demand inspired the development of specialized CellDrop applications for hepatocytes and organoids.
Could you start by giving us an overview of the CellDrop Automated Cell Counter and what inspired DeNovix to develop specialized applications for hepatocytes and organoids?
The inspiration was our customers who kept requesting these applications. Hepatocyte counting was one of the first requests we received before the CellDrop was even released and we were showing Beta units to labs for feedback. Organoid analysis was also requested by an overwhelming number of customers a few years ago and the demand really hasn’t slowed.
Image Credit: Choksawatdikorn/Shutterstock.com
Image Credit: Choksawatdikorn/Shutterstock.com
Hepatocytes and organoids are notoriously tricky to count accurately. What makes these cell types particularly challenging for traditional counting methods?
Traditional automated cell counting algorithms are looking for either bright or dark objects that are small and round and stain evenly against the background. These algorithms do great with tissue culture cells or many types of primary cells, especially when using fluorescence. In contrast, hepatocytes and organoids are irregularly shaped with many internal structures and tend to be grown in complex environments with many other objects, such as debris or other cell types. Since these samples have a lot of internal structure or, in the case of organoids, many dozens or hundreds of cells per object, it is difficult to get even staining. These factors combine to make these sample types nearly impossible to count accurately using traditional cell counting algorithms.

Hepatocytes result image from the CellDrop FLi Automated Cell Counter.

Organoids result image from the CellDrop FLi Automated Cell Counter.
How does the machine learning approach behind CellDrop’s algorithms differ from more conventional image analysis techniques for cell counting?
The machine learning models are trained to count objects of interest, be it hepatocytes, organoids, or some other type of cell in the sample, as a scientist with many years of experience would count them. In each case, we used hundreds of images with tens of thousands of different objects. We assigned each object to a specific class, for example, an organoid, a dissociated cell, or a debris particle. We then trained the algorithm on this data set and tested it with different types of fresh samples. We further refined the algorithm until it gave the same results as our trained scientists would for the sample type it was trying to count. It’s a labor-intensive process, but the results are undeniable for complicated sample types.
Could you describe how the hepatocyte counting algorithm was trained, including what datasets or validation processes were involved to ensure accuracy?
We used a wide variety of source material to train the algorithms. Hepatocytes from a range of species were used, including freshly isolated tissue and cryo-thawed hepatocytes. In addition to having significant expertise amongst our applications team, we worked with industry-leading suppliers of hepatocytes and research labs that helped train us to count hepatocytes as they would count them. These labs were then able to successfully verify the performance of the finished algorithm in their labs on a range of samples.
Organoids can vary significantly in size, shape, and structure. How did you adapt your algorithm to account for this variability while maintaining reliable counts?
As with hepatocytes, we found some great partners to help us produce organoids and tumorspheres and direct us in counting them as they would. They helped train our team on the most important parameters when counting these samples and guided us on the quality metrics we have included in the software.
What benefits have you seen customers gain from the automated counting of these complex cell types in terms of data quality and workflow efficiency?
When a customer counts a sample manually, like they would have had to do previously for an organoid or a hepatocyte sample, there is naturally going to be variation from person to person or lab to lab in how the same samples are counted. The great benefit of automating this process is that you can imagine a scenario with two collaborating labs, each with 10 people, counting the same samples with slight variation. Introduce automation, and now you have 20 people counting the samples using the same method.
Automated counting algorithms can also give QC information about the sample, such as how much debris is present or the average diameter of the cells, which manual cell counts would not easily capture. For regulated environments, the addition of tools such as IQOQ or 21 CFR pt 11-ready software also makes compliance a lot easier.
Are there any limitations or edge cases your team had to overcome where the algorithms initially struggled, and how did you address them?
I have never worked on a project without unexpected challenges. The nature of biology is that there are always exceptions, and these will have to be understood and handled in the best way for the customer. Our applications team has a wealth of experience in this field and is adept at helping our customers optimize their setup.
Looking ahead, do you see opportunities to expand machine learning–based counting to other specialized or hard-to-measure cell types?
Well, I can’t give away too much here, but let’s say that we plan to continue using our machine learning technology to address the needs of our customers who have difficult cell counting or related QC challenges in their workflows.
Finally, if you had to summarize the key advantage of using CellDrop for hepatocyte and organoid counting in just one sentence, what would it be?
The CellDrop allows for the fast, accurate, and reproducible standardization of hepatocyte and organoid counts in any lab that uses these sample types without requiring disposable plastic slides.
Eliminate Costs | Automate Cell Counting
About Dan Schieffer
Dan Schieffer is Scientific Director at DeNovix and the lead CellDrop development scientist. Before joining DeNovix, Dan was a student and researcher in cell and molecular biology at Villanova University and the University of Pennsylvania.
researcher in cell and molecular biology at Villanova University and the University of Pennsylvania.
About DeNovix Inc.
Award-winning products for Life Science
DeNovix multi-award winning products include the Reviewers’ Choice Life Science Product of the Year and Platinum Seal awarded- DS-11 Series Spectrophotometer / Fluorometer and CellDrop™ Automated Cell Counter. CellDrop is the first instrument of its kind to Count Cells Without Slides. These powerful instruments integrate patented DeNovix technology with easy-to-use software designed by life scientists for life scientists.
Researchers report they love the industry leading performance, smart-phone-like operation, and the flexible connectivity of the instruments. When support is needed, the DeNovix team is here to help. DeNovix received the prestigious Life Sciences Customer Service of the Year based on independent reviews posted by scientists worldwide!
CellDrop: Sustainable laboratory product of the year
The CellDrop Automated Cell Counter has been awarded Sustainable Laboratory Product of the Year in the SelectScience® Scientists’ Choice Awards®!
CellDrop’s patented DirectPipette™ technology distinguishes it as the only cell counter to eliminate the need for cell counting slides. This innovation saves millions of single-use plastic slides from use and disposal each year.